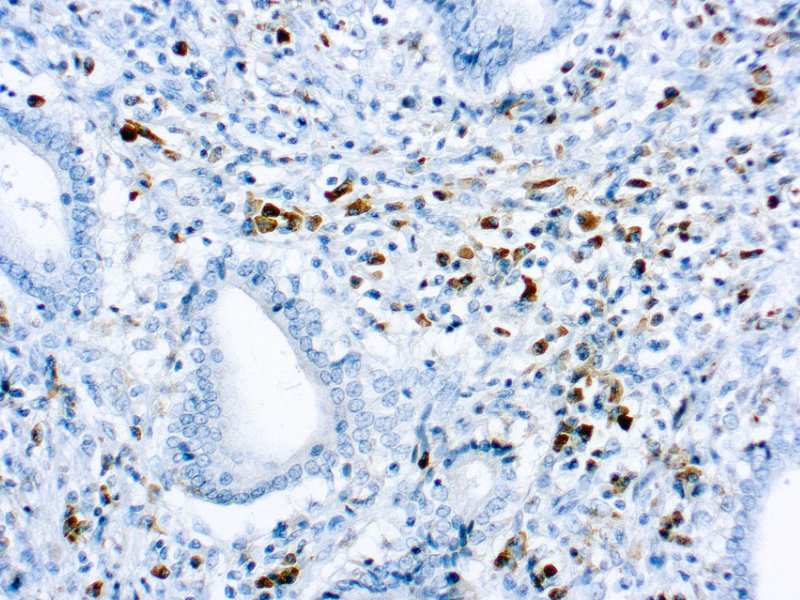

This antibody reacts with free as well as bound kappa light chains. Contaminating antibodies have been removed by solid phase adsorption.
Kappa Light Chain (Rabbit)
SKU: 5273
Categories: Primary Antibodies, IVD - For U.S. Market, IVD - Outside U.S. Market
Tags: Concentrated, K
Description
Additional information
| Clone | Rabbit |
|---|---|
| Immunogen | kappa light chains isolated from pooled urine of patients with Bence Jones proteinuria. |
| Species | Rabbit |
| Cellular Localization | Cytoplasmic |
| Positive Control Tissue | Tonsil |
| Pretreatment | Citrate Buffer pH 6.0 |
| Incubation & Temperature | 30 min @ RT |
| Intended Use | IVD |
| Detection System | PolyVue Plus – Two Step Detection System or Montage PolyVue Plus Auto Detection System for Montage 360 System |
| Description/Type | Rabbit Polyclonal Antibody |
| Format | Purified immunoglobulin fraction of rabbit antiserum against Kappa light chain containing sodium azide as a preservative. |
DATASHEETS & SDS
DATASHEETS & SDS
| Download Datasheet |
| Download SDS Sheet – OSHA |
Reviews (0)
Only logged in customers who have purchased this product may leave a review.

Reviews
There are no reviews yet.